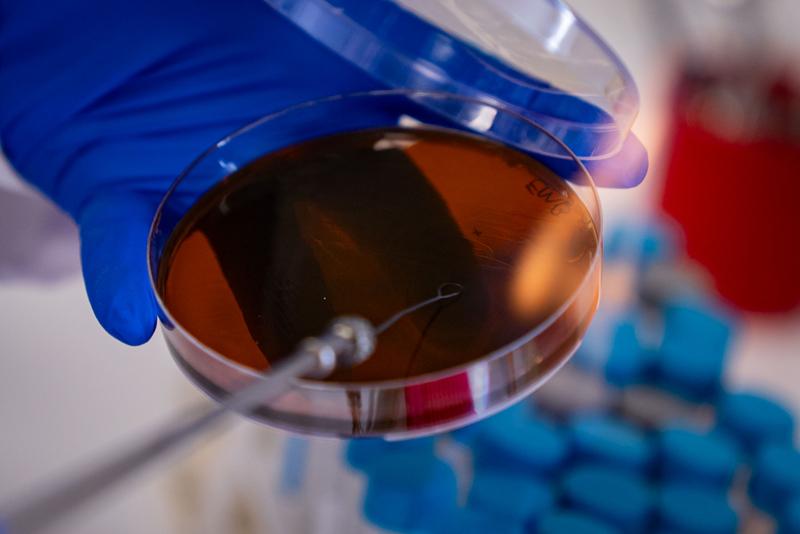

SBÜ Gülhane Temel Tıp Bilimleri Anabilim Dalı Tıbbi Mikrobiyoloji Biyoteknoloji Uzmanı Prof. Dr. Gülçin Alp Avcı, kişiye özel probiyotik üretimi çalışmalarına ilişkin açıklamada bulundu.
Probiyotiklerin canlı mikroorganizmalar olduğunu belirten Avcı, "Mutlaka doğru ürünü seçmek zorundayız. Ne kadar fazla gereksiz mikroorganizma tüketirsek o kadar fazla da vücuttan tepkiler oluşabiliyor." dedi.

Prof. Dr. Avcı, en çok gündemde olan hastalıklardan birinin şu anda SİBO olduğunu ifade ederek, "İnce bağırsaklarda bakterilerin aşırı çoğalmasını gözlemliyoruz. Bilinçsizce bakteri kullandığımızda bunu çok normal görebiliyoruz. Bu yüzden kişiye özgü özel olarak seçilmiş probiyotikleri kullanmakta fayda var. SBÜ Teknoloji Merkezi'nde kişiye özel probiyotik ürünler çalışıyoruz. Mikrobiyota analizi yapılıyor. Canlı flora bakıyoruz. Kişinin klinik bulguları, şikayetleri, istekleri, talepleri, hekiminin taleplerini alıyoruz." diye konuştu.

"BAĞIRSAK NE KADAR İYİYSE BEYİN DE O KADAR SAĞLIKLI ÇALIŞIYOR"
Probiyotik kullanımı için sadece hasta olmak gerekmediğinin altını çizen Avcı, "Sağlıklı ve kaliteli yaş almak istiyorsak mutlaka probiyotik desteğine ihtiyacımız var. Son zamanlarda bağırsaklar, ikinci beyin olarak adlandırılıyor. İkinci beyin diye görüyoruz ama beynin tüm fonksiyonlarını yerine getirebilmek için beslenmeye ihtiyacı var. Vücudun beslenmesi ne kadar iyiyse beyin o kadar sağlıklı çalışabiliyor. Besinlerin de sağlıklı ayrıştırılması bağırsaklarda meydana geliyor." dedi.
Avcı, bağırsak florasının sağlıklı, düzenli ve uyum içerisinde çalışmasının immün sistemini de dengelediğini ifade ederek, "Seratonin, melatonin gibi uyku sağlığını, mutluluğumuzu destekleyecek hormonlar ve enzimler de buralardan geçtiği için florayı ne kadar sağlıklı ve dengeli tutabilirsek vücut aslında kompleks bir yapı olarak tamamen sağlıklı hareket edebiliyor." dedi.

"KİŞİYE ÖZEL PROBİYOTİKLER HER YAŞTA KULLANILABİLİR"
Probiyotiklerin üretim aşamalarına ilişkin de bilgi veren Avcı, şunları kaydetti:
"Kişisel olarak başvuru da alabiliyoruz. Sağlık Bilimleri Üniversitesi'nde bu işin yapıldığını bilen hekimler, diyetisyenler bizlerden destek alabiliyorlar. Onların danışanlarını ya da hastalarını yönlendirmesiyle yine mikrobiyota analizi sonucunda probiyotik ürünler geliştirilebiliyor. Burada önemli olan hekim ve diyetisyenin de üç sac ayağı kurgulayıp sistemi ilerletmesi, hastalıkların ilerleyişi anlamında bize çok destek oluyor."
Avcı, başvurular alındıktan sonra bireylerden gaita analizi yaptıklarını ve bu analiz sürecinin yaklaşık 3 hafta sürdüğünü ifade ederek, "Moleküler çalışmalar yapıyoruz, canlı flora çalışıyoruz. Sonrasında kişilerin şikayetleri, talepleri doğrultusunda bir profil oluşturuyoruz. Bilimsel olarak hangi bireyde, hangi mikroorganizma, hangi oranda olmalı ona karar verip probiyotik ürün tercihini ona göre yapıyoruz." dedi.
Kişiye özel probiyotiklerin her yaşta kullanılabildiğini dile getiren Avcı, "Gebelerde genellikle hekiminin önerisi doğrultusunda, kullanıp kullanmamayı hekime bırakıyoruz. Yenidoğan bebeklerde ise ek gıdaya başlamadan önce anne sütü ile destek olabiliyoruz. 93 yaşında bugün destek olduğumuz hastalarımız da var. Her hasta grubuna farklı flora üyeleriyle destek olunabilir." ifadesini kullandı.

KİŞİYE ÖZEL PROBİYOTİK KULLANIM SÜRESİ EN AZ 6 AY
Prof. Dr. Avcı, kişiye özel probiyotiklerin tüm hastalıklar için kullanılabileceğini belirterek, "Bağırsaktan bahsediyorsak, tüm hastalıklardan bahsedebiliriz. Nörolojik bir bozukluk da olabilir. MS, parkinson, Alzaymır, demans ve otizm gibi nörolojik bir bulgu olabilir. İç organlarla ilgili akciğer, karaciğer, böbreklerle ilgili problem olabilir. Kemik, eklem rahatsızlığı söz konusu olabilir. Bütüncül bakmak lazım. Herhangi bir bölgede moleküler olarak iletişim sağlanacaksa vücudumuzda temeli bağırsaklardan geçiyor. Yediğimiz, içtiğimiz şeyle hayattayız, onun da düzgün sindirilip tüm vücuda yayılabilmesini bağırsaktaki flora sağlıyor." diye konuştu.
Kişiye özel probiyotiklerin en az 6 ay kullanılması gerektiğini belirten Avcı, "Canlı bir floradan bahsediyoruz. Bağırsaklara yerleşmesi, oraya adapte olması gerekiyor. Bu konuda sonuçlar da gerçekten yüz güldürücü. İnsanlar genellikle bize tavsiye üzerine geliyorlar. Özellikle hekimlerinin tavsiyesi üzerine geliyorlar. Kullandıkları ikinci aydan itibaren çok güzel, olumlu geri dönüşler oluyor. Tavsiye ediyorlar devamlı ve bu bizim için çok sevindirici." dedi.

"PROBİYOTİKLER UZMAN GÖRÜŞÜ DAHİLİNDE KULLANILMALI"
Prof. Dr. Avcı, probiyotiklerin mutlaka bir uzman görüşü ile kullanılması gerektiğini vurgulayarak, şu uyarılarda bulundu:
"Hem dünyada hem de ülkemizde bilinçli antibiyotik kullanımı altını çizdiğimiz çok önemli bir konu. Probiyotikler de öyle. Hekim önerisi ya da bu işi çalışan bir uzmanın önerisi olmadan kafamıza göre probiyotik almamalıyız. Mikroorganizmalar da bir sürü metabolit üretiyor. İyi mikroorganizma diye de bağırsak floramızdaki dengeyi bozmamak lazım. Antibiyotik kullanıyorsak eş zamanlı probiyotik veriliyor ama orada da şuna dikkat etmek lazım; biz antibiyotikleri bakterileri öldürmek için kullanıyoruz. Probiyotik olarak kullandığımız ürünlerin içerisinde de yüzde 90'dan fazla bakteri var. Eş zamanlı kullanacaksak, hangi antibiyotik hangi probiyotikle mutlaka bir uzman görüşü dahilinde kullanmakta fayda var."




